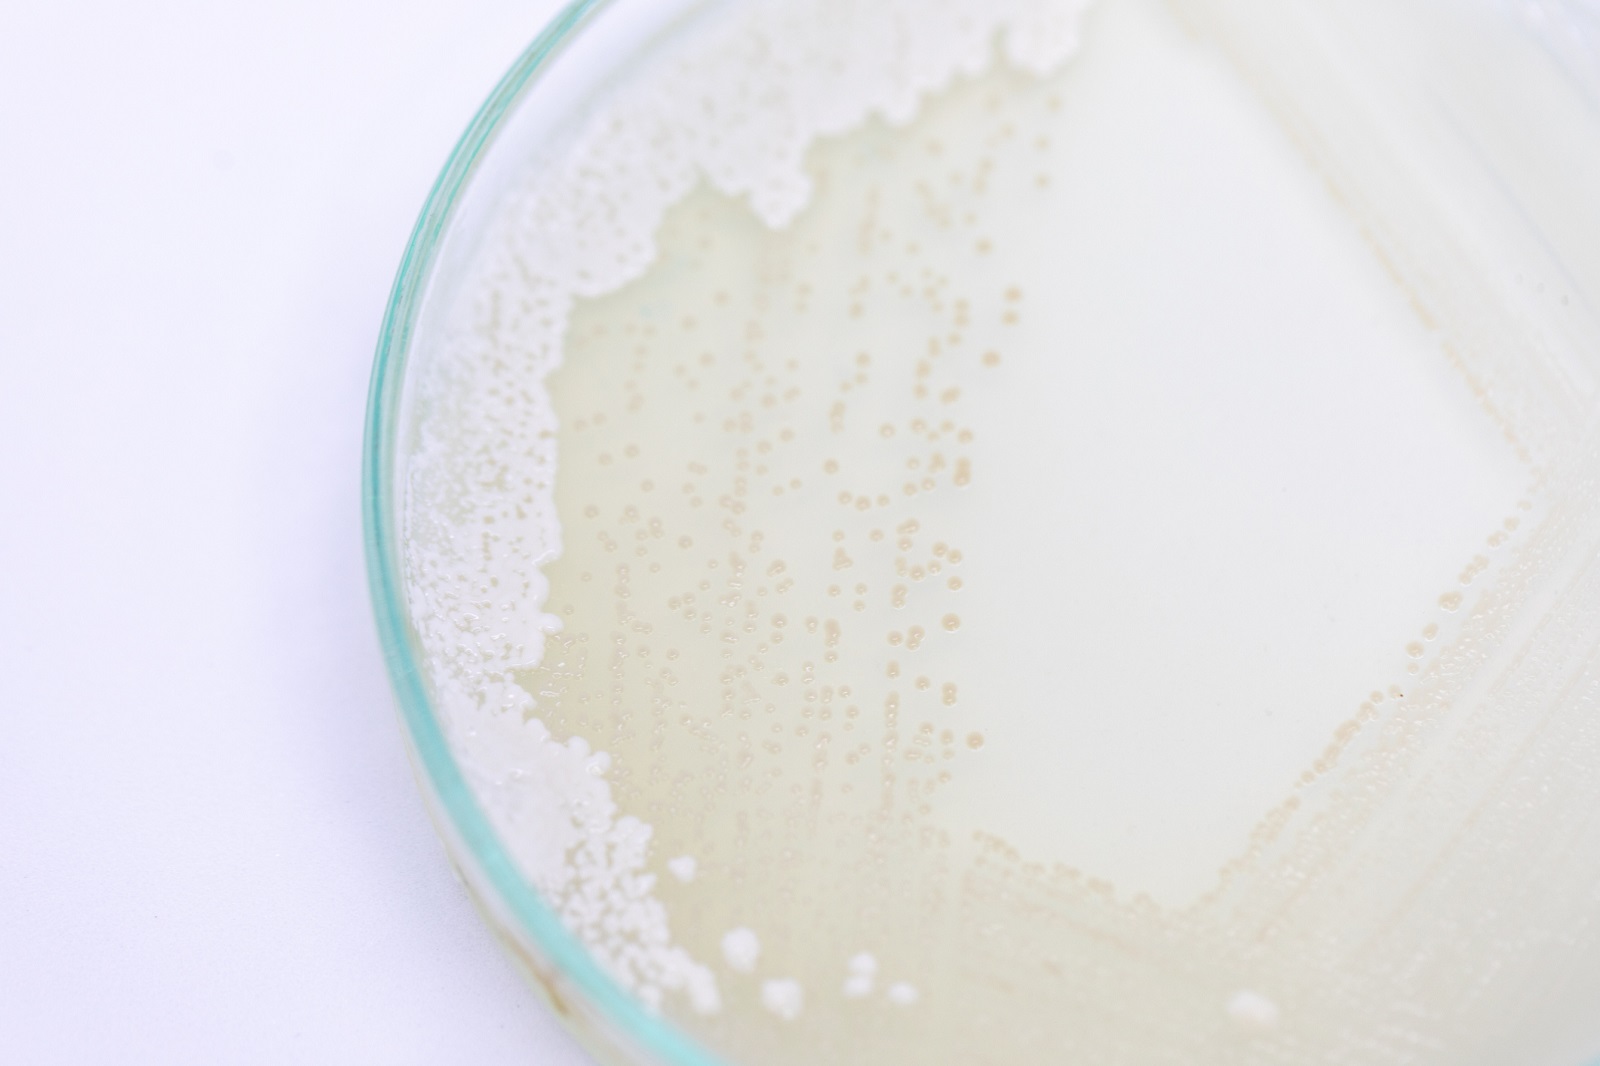

Na czym polega bioprotekcja mleka?
Nawet osobom, które niezwiązane są z branżą mleczarską, zdarzało się usłyszeć zwrot „bioprotekcja mleka”. Nic w tym dziwnego. Szczepionki mleczarskie mają ogromny wpływ na wyroby mleczne, które spożywamy. Czym dokładnie jest bioprotekcja mleka i dlaczego jest nam potrzebna? Sprawdźmy!
Szczepienie mleka
Bioprotekcja mleka polega na dodawaniu do przetworów mlecznych odpowiednio wyselekcjonowanych kultur bakterii. Mają one pozytywny wpływ nie tylko na smak i wygląd gotowego sera, mleka czy jogurtu, ale też zatrzymują rozwój bakterii, które są szkodliwe dla zdrowia człowieka. Szczepienie mleka umożliwia mu także nadanie właściwości prozdrowotnych. Odpowiednie szczepionki wyrobach mleczarskich dbają o poprawne funkcjonowanie flory bakteryjnej w naszych żołądkach, a także wspierają nasze organizmy w walce z wirusami i szkodliwymi bakteriami. Probiotyczne jogurty są także wspaniałą osłoną dla naszych jelit i dróg moczowo-płciowych.
Rodzaje szczepionek do serów
Boprotekcja jest skuteczna tylko wtedy, gdy do danego przetworu mlecznego zostanie dodany odpowiedni szczep bakterii. Jest to kluczowe zwłaszcza w przypadku produkcji serów. Różne jego gatunki wymagają różnych szczepionek. Szczepionki do sera możemy podzielić na mezofilne i termofilne. Pierwsze znajdują zastosowanie przy produkcji serów w temperaturze nieprzekraczającej 38oC, tj. świeżych, pleśniowych i półtwardych. Drugie z kolei dodaje się do serów wytwarzanych w zakresie temperatur 40-60oC, takich jak mozzarella czy twaróg. Szczepionki można podzielić też ze względu na ich działanie. Tu wyróżniamy kultury startowe odpowiedzialne za proces fermentacji mleka i kultury uzupełniające, które nadają produktowi dodatkowe cechy smakowe lub wizualne. Zamawiając szczepionkę do sera, zamawiający musi więc doprecyzować, czy interesują go bakterie do sera Edam, Tylżyckiego, Gouda, Salami itp. Wcześniej wspomniane szczepionki mezofilne stosuje się też bardzo często w procesie zakwaszania mleka i śmietany.